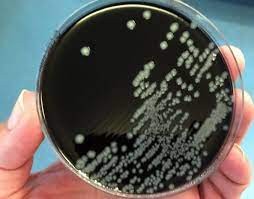
تنزيل (5).jpg

تلعب البكتيريا التي تعيش في أحشائنا دورا مهما في قدرتنا على هضم الطعام ومحاربة الأمراض، وتحتوي جميع الحيوانات الأخرى أيضا على مجتمعات من البكتيريا تعيش بداخلها والتي تعرف باسم الميكروبيوم، ويمكن أن يساعد التعرف عليها العلماء في تكوين صورة أكثر اكتمالا عن كيفية تفاعل تلك الحيوانات مع العالم.
في دراسة جديدة في دورية "مولكيولار إيكولوجي" (Molecular Ecology) نشرت يوم 28 سبتمبر/أيلول الماضي، استخدم الباحثون أجهزة تعقب راديوية صغيرة لمتابعة تحركات الطيور التي تهاجر بين جزر البهاما وولاية ميشيغان، ووجدوا أن بكتيريا أمعاء الطيور نفسها كانت مختلفة في الموقعين، ولمعرفة ذلك كان على العلماء الاقتراب والتعامل مع الكثير من فضلات الطيور.
طير نادر لدراسة أدق
في التقرير الذي نشره موقع "فيز دوت أورغ" (Phys.org) عن البحث، تقول هيثر سكين طالبة الدكتوراه في "متحف فيلد" (Field Museum) و"جامعة شيكاغو" (University of Chicago) والمؤلفة الرئيسية للدراسة، "رأينا في حيوانات أخرى أن الميكروبات يمكن أن تتأثر بالأماكن التي يعيش فيها مضيفوها، فالكثير من الطيور تهاجر وتختبر بيئات مختلفة في نقاط مختلفة من دورة هجرتها، ولم نكن نعرف كيف تؤثر هذه البيئات المختلفة على ميكروبيوم الطيور".
كما يقول شانون هاكيت الأمين المشارك لمتحف فيلد "تُظهر هذه الدراسة مقدار ما يمكننا تعلمه عن الجوانب الأساسية لبيولوجيا الطيور مثل الهجرة، بالجمع بين التقنيات الجديدة والقديمة، من العمل الميداني ومتابعة الطيور في موائل تكاثرها وهجرتها وشتائها، وصولا إلى أحدث تقنيات القياس الراديوي وتسلسل الجيل التالي من الحمض النووي".
بينما تهاجر الآلاف من أنواع الطيور، قامت سكين وزملاؤها بالتركيز على نوع واحد فقط لهذه الدراسة: هازجة كيرتلاند (Kirtland’s Warbler)، وهو أحد أندر الطيور في العالم، وهي طيور مغردة صغيرة صفراء الصدر تقضي فصول الشتاء في جزر البهاما وتهاجر إلى شمال ميشيغان في الربيع، حيث تتكاثر فقط في غابة الصنوبر الصغيرة.يقوم الباحثون بعمل ميداني ووضع أجهزة تعقب راديوية على هازجة كيرتلاند في جزر البهاما (أدريان ديل – الصحافة الأميركية)
وقد كاد هذا الطائر أن ينقرض في القرن الـ20، وانخفضت أعداده إلى 167 ذكرا فقط في البرية في عام 1987، لكن أعداده استقرت بفضل جهود الحفظ المكثفة على مناطق التكاثر.
مع ذلك فهو نادر في عالم الطيور، وهذه الندرة -إلى جانب انتقائيته الشديدة لمناطق التكاثر- جعلته مثاليا لهذه الدراسة، تقول سكين "اخترنا طيور هازجة كيرتلاند نظرا لوجود عدد قليل جدا من أنواع الطيور التي كان من الممكن لنا أن نتتبع أفرادا منها من المناطق التي لا تتكاثر فيها، ثم الإمساك بها في مناطق تكاثرها".
إن محاولة تتبع أفراد من الطيور الشائعة للغاية والمنتشرة على نطاق واسع مثل "روبينز" (robins) كانت ستبدو مثل محاولة العثور على إبرة في كومة قش، لكن مع هازجة كيرتلاند فإن كومة القش أصغر بكثير، ومنتشرة على مساحة جغرافية أصغر بكثير.طائر هازجة كيرتلاند مع جهاز تتبع راديوي صغير على ظهره (هيثر سكي-الصحافة الأميركية)
فضلات الطيور لدراسة الميكروبيوم
بدأ الباحثون بالقيام بعمل ميداني في جزر البهاما، حيث قاموا باجتذاب هازجة كيرتلاند بأصوات نداء طيور مسجلة، وزودوها بأجهزة تتبع راديوية صغيرة، ولأن الطيور نفسها صغيرة الحجم -ما يزيد قليلا عن 14 غراما- فقد كان وزن أجهزة التتبع أقل من نصف غرام.
وبعد إرفاق أجهزة التتبع، وضعت سكين وزملاؤها الطيور داخل أكياس ورقية من الشمع لبضع دقائق، حيث قامت الطيور على الفور بتحويل الأكياس إلى حمامات خاصة بها، ثم تم إطلاق سراح الطيور وبدأت سكين بجمع عينات الفضلات.
بعد بضعة أشهر، وعندما هاجرت الطيور من جزر البهاما إلى ميشيغان، استخدمت سكين وزملاؤها شبكة كبيرة من أبراج الراديو الآلية -المعروفة باسم نظام موتوس لتتبع الحياة البرية (Motus Wildlife Tracking System)- لتحديد مواقع أفراد الطيور نفسها التي أخذوا منها عينات الفضلات في جزر البهاما.
تقول سكين "كان هناك 12 برجا لاسلكيا منتشرة في جميع أنحاء منطقة تكاثر الطيور في ميشيغان، وعند التقاط إشارة أحد أجهزة تعقب الطيور لدينا بالقرب من أحد الأبراج، كنا نتجول في نطاقه باستخدام هوائي راديو محمول بحثا عن الطائر، وبمجرد أن نلتقط الإشارة، نتجول في الأنحاء محاولين جذب الطيور باستخدام تسجيلات تغريداتها".
وعندما سقطت الطيور في الشباك التي أقامها الباحثون، كرر العلماء إجراء الأكياس الورقية قبل السماح للطيور بالذهاب مرة أخرى.أجرى الباحثون تحليلات جينية للبكتيريا الموجودة في الفضلات (غيتي)
بكتيريا مختلفة
بالتزود بما يقرب من 200 عينة من فضلات الطيور وعينات من أفراد الطيور نفسها في كل من جزر البهاما وميشيغان، أجرى الباحثون تحليلات جينية للبكتيريا الموجودة في الفضلات، ووجدوا أن البكتيريا الموجودة في عينة ميشيغان كانت مختلفة عن البكتيريا الموجودة في البهاما، وأن أفراد الطيور نفسها لديها بكتيريا مختلفة في قنواتها الهضمية اعتمادا على مكان وجودها عندما تم جمع الفضلات.
"أحد أهم أجزاء هذه الدراسة هو أننا كنا قادرين على استعادة الطيور في أجزاء مختلفة من الدورة السنوية في مواقع مختلفة، ولدينا هذه المقارنة الفردية بين الأعداد ذاتها والأفراد نفسها وكيفية تغير الميكروبيوم، فإذا كنا اختبرنا أفراد طيور مختلفة، فلن نكون قادرين على التأكد مما إذا كانت التغييرات التي رأيناها ترجع إلى الموقع أم أنها مجرد اختلافات بين المجموعات السكانية".
يمكن أن تساعد نتائج الدراسة التي تفيد بأن ميكروبيومات الطيور تختلف من مكان إلى آخر حتى داخل نفس الأفراد، العلماء في حل لغز كيفية عمل ميكروبات الطيور، وتشرح سكين قائلة "نعلم أن ميكروبيوم الطيور يختلف عن معظم الثدييات، لكننا لا نعرف بالضبط كيف ولماذا". ففي معظم الثدييات ترتبط أنواع بكتيريا الأمعاء الموجودة ارتباطا وثيقا بأنواع الحيوانات وتاريخها التطوري، ولكن مع الطيور تبدو هذه الروابط أكثر مرونة.أشارت الدراسات السابقة إلى أن ميكروبات أمعاء الطيور لها علاقة بالمكان الذي تعيش فيه أكثر من النوع (غيتي)
وبدلا من ذلك أشارت الدراسات السابقة إلى أن ميكروبات أمعاء الطيور لها علاقة بالمكان الذي تعيش فيه أكثر من ارتباطها بالأنواع التي تنتمي إليها، وتضيف سكين "في دراستنا، وجدنا أن هناك بعض مجموعات البكتيريا التي من المحتمل أن تكون عابرة، تكتسبها الطيور من خلال طعامها، وتخرجها ومن ثم تختفي، فهذه البكتيريا لا تستعمر الطيور".
ولاحظت سكين أيضا أن أزمة المناخ قد تجعل ميكروبيوم الأمعاء مهما بشكل خاص حيث تحاول الحيوانات البقاء على قيد الحياة في البيئات المتغيرة، تقول "إن ميكروبيوم أمعاء الحيوان هو مستوى إضافي من التنوع الجزيئي، وبما أن تغير المناخ العالمي يغير النظم البيئية، فقد يكون ميكروبيوم الأمعاء أحد السبل التي يمكن للحيوانات أن تتكيف من خلالها مع البيئة المتغيرة، فالميكروبيوم المعوي له نظامه البيئي الفريد الخاص به، وهو غني بالاكتشافات".